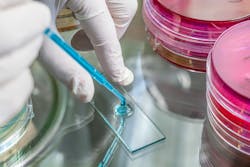
KatarzynaBialasiewicz/iStock KatarzynaBialasiewicz/iStock

Legionellosis prevention in industrial equipment
Legionellosis is the most significant waterborne disease in the U.S. and possibly in many other developed countries with plumbing and other water handling systems. It accounted for about two-thirds of identified waterborne disease outbreaks included in the last two Centers for Disease Control and Prevention (CDC) “Mortality and Morbidity Weekly Reports” (MMWR) on drinking water, and it is the only one that caused deaths.
The route of infection is not from ingesting drinking water but from inhalation of aerosols. Legionella pneumophila bacteria are ubiquitous in the environment in soil and water. The bacteria cause Legionnaires disease and the less virulent Pontiac fever, which are types of pneumonia. The most susceptible populations include the elderly, smokers, people with weakened immune systems or those on immune suppressant therapy. The microorganisms regrow in biofilms in warm water temperatures between about 20ºC and 50ºC (68ºF to 122ºF). The challenge is to prevent and remove the biofilms from plumbing and heat exchangers so they will not have a protected reservoir that can be colonized by Legionella pneumophila and other regrowth pathogenic microorganisms.
Legionnaires’ disease
Legionnaires’ disease got its name from its first detection and identification during the 1976 American Legion Convention at a hotel in Philadelphia. Several months after the occurrence and following intensive laboratory method development studies, the bacteria were cultured and identified as the causative agent in the 34 deaths of convention attendees. Blowdown of aerosols from a rooftop cooling tower at the hotel caused the exposures. Pontiac fever had been known for many years prior, but the causal microorganisms had not been identified.
Legionellosis has been a reportable disease in the U.S. only since 2001. The CDC has estimated that between 8,000 and 18,000 people in the U.S. are hospitalized each year with Legionellosis. The European Union Center for Disease Prevention and Control reported 5,851 identified cases in 2013, which is surely an underestimate, and it did not specify the role of water. The death rate was about 10 percent, with people more than 50 years old accounting for 81 percent of the cases.
Since 1976, Legionellosis outbreaks have been regularly identified in association with plumbing and other water facilities. Hospital, health-care and long-term-care facilities accounted for 80 percent of the MMWR outbreaks and deaths. Reported outbreaks also occurred in hotel/motel and other lodging environments, apartments and condos, indoor workplace/offices, factory industrial settings, a mobile home park, a resort and a multiuse facility.
New York City Legionellosis outbreak
A recent reported example of the commonality of Legionellosis cases from non-drinking water outbreaks occurred in New York City. Cases of Legionellosis were occurring in July 2015 near several hotels in The Bronx, New York. Mists from up to 15 rooftop heat exchanger cooling towers on buildings were implicated because water testing detected legionella with the same serotype found in infected people. The cooling towers were cleaned and disinfected yet Legionella microorganisms were again found in the towers when they were retested two months later. The final outbreak count was 133 cases with 16 deaths.
Water sources & growth conditions
While plumbing’s role in bacterial growth is well recognized, although not resolved, this article focuses on commercial, institutional and industrial water aerosol exposure situations. The Occupational Safety and Health Administration (OSHA) describes growth conditions that include heat that maintains water in the ideal growth temperature range, sediment, scale, supporting microflora (such as algae), amoebae (which often colonize the biofilms), and a pH between 5.0 and 8.5. It lists the following origin waters:
- Cooling towers, evaporative condensers and fluid coolers that use water
- Domestic hot water systems operating below 60ºC and delivering water to taps below 50ºC
- Humidifiers and decorative fountains with water spray, especially at favorable growth temperatures
- Spas and whirlpools
- Dental water lines
- Stagnant water in fire sprinklers, warm water in eye wash systems and safety showers
Commercial, industrial & non-hospital outbreaks
Detection of hospital, nursing home, hotel and domestic Legionellosis cases and outbreaks are becoming common as better and more frequent diagnostic testing occurs. The continuing detection of non-hospital, non-hotel and non-residential outbreaks demonstrates the risks that can exist in commercial and industrial environments. Recent examples include:
- In Hopkins, Minnesota, in September 2016, 23 cases were diagnosed with one death. A cooling tower at a beverage plant was the likely source according to officials.
- In Marietta, Georgia, in July 2016, a plant had two workers diagnosed with Legionnaires disease. The source was not determined.
- In February 2016, a New England worker near a cooling tower contracted the disease and later transmitted it, probably by coughing, to his mother who was caring for him. Both died.
- More than 230 cases with three deaths occurred near Manzanares, Spain, in January 2016. An ornamental fountain was the suspected source of exposure.
- In April 2015, five cases, including four employees and one nearby resident, were reported near an auto parts factory in Boldon, U.K. Two cooling towers were the suspected sources. The plant is replacing the towers with closed systems.
- A cooling tower at a fertilizer plant near Lisbon, Portugal, was the suspected source of 311 cases and seven deaths in November 2014.
Preventive measures
Reducing the potential for Legionellosis or Pontiac fever cases in commercial and industrial environments requires managing the facilities that can produce aerosols of warm water with the potential to expose workers and others near the facility. Cooling towers and heat exchangers that produce mists should be cleaned regularly, continuously disinfected and periodically monitored according to the CDC and other recommendations. Silver/copper disinfection has been effective in hospital/building plumbing conditions.
Recommended preventive practices for HVAC facilities from the Utah Department of Health include:
- The continuous use of chlorine or other halogen disinfectants and maintaining residuals
- Minimizing the use of water reservoirs, sumps and pans
- Draining water sumps when they are not in use, sloping and designing sumps so they can be drained from the bottom, and allowing the pan to dry
- Locating air intakes so they do not draw mist from a cooling tower, evaporative condenser or fluid cooler
- Keeping complete maintenance records to ensure that management is continuous
Decorative fountains and waterfalls require regular cleaning and the continuous use of a biocide. Filters are suggested, although the appropriate porosity, replacement rate, and what is intended to be filtered, are not clear. Although a filter would reduce turbidity, biofilms and nutrients could accumulate on filters and become sites for regrowth microorganism breeding sites.
Remediation
The relationship between water or vapor and concentrations of infectious Legionella microorganisms and infective doses has not been well established. The susceptibilities of at-risk populations and exposure conditions are varied. Quantitative interpretation of water monitoring results is not clear other than that the ideal is not to detect any pathogenic microorganisms in the water and biofilms as a result of using validated test methods and recommended monitoring frequencies.
In domestic or building plumbing, typical remediation usually includes shock treatments to eliminate the biofilms. This could be accomplished by maintaining water temperatures higher than 70ºC, followed by detergent cleaning and high-dose, disinfectant shock treatments including high chlorine or other oxidizer doses. This should be followed by flushing and the introduction of an oxidizer or silver/copper for continuous residual maintenance.
Cooling towers should be drained, cleaned and disinfected with retention of a residual disinfectant. HVAC systems are complex and require draining, eliminating sources of stagnant water and accumulated condensate or vaporizers, and cleaning and disinfecting.
Detailed recommendations for prevention, management, monitoring and remediation are provided in several publications, including:
- The OSHA Technical Manual, Section III: Chapter 7, available at http://osha.gov/dts/osta/otm/otm_iii/otm_iii_7.html or http://cdc.gov/legionella/index.html
- American Society of Heating, Refrigerating and Air-Conditioning Engineers Standard 188-2015: Legionellosis: Risk Management for Building Water Systems, available at http://ashrae.org
Conclusion
Legionellosis cases and deaths occur worldwide and are being detected in increasing numbers. These increases are most likely because of better detection and diagnoses rather than increases in actual cases since the causal factors – hot water plumbing, fountains and heat exchangers – have been present for more than 100 years. Smoking rates are lowering in most societies. However, the number of other at-risk individuals, who are older and already bearing some illness and with some degree of immunity suppression, is increasing. Although hospitals and long-term care facilities have concentrations of high-risk individuals and show numerous outbreaks, commercial facilities – including hotels, public fountains and industrial facilities – are also sources of reported legionellosis outbreaks worldwide.
Those facilities must take steps to reduce public and employee exposures to aerosols from HVAC, heat exchangers and cooling towers to reduce their liability if a case of disease is detected. Advice is widely available, especially on warm water management, detection methods, prevention and remediation. It should be noted that the addition of supplemental treatment to a drinking water supply intake could result, in some states, in the facility being designated a public water system and becoming subject to Safe Drinking Act regulations including monitoring, operator training and reporting requirements. This is an irrational situation and counterproductive, and it could be remedied by the U.S. Environmental Protection Agency, but it has not been.
Joseph Cotruvo, Ph.D., BCES, is president of Joseph Cotruvo and Associates LLC, water, environment and public health consultants, and technical editor of Water Technology. He is a former director of both the EPA Drinking Water Standards and the Risk Assessment Divisions.